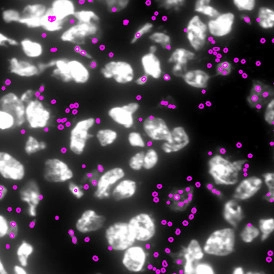

PD-L1 raises new hope in the treatment of cutaneous leishmaniasis
PD-L1 expression has emerged as a predictor of treatment response in cutaneous leishmaniasis. Using StrataQuest image analysis, researchers quantified immune markers and parasites, highlighting PD-L1 as a potential host-directed therapeutic target.
White Paper

PD-L1 raises new hope in the treatment of cutaneous leishmaniasis
25 Jan, 2022
Cutaneous leishmaniasis (CL) caused by infection with the Leishmania protozoan is endemic in Sri Lanka. The disease is transmitted by the sandfly and causes widespread burden due to the social stigma causing sufferers to be ostracized and forced into financial hardship. Treatments for cutaneous leishmaniasis have limited success and so, once contracted, patients often face a lifetime of misery.
Recent research showing that programmed death-ligand 1 (PD-L1) expression is predictive of clinical response to treatment in patients with leishmaniasis has raised hopes that PD-L1 could provide a much-needed host-directed therapeutic with the potential to cure leishmaniasis.
Cutaneous leishmaniasis
This parasitic tropical disease is caused by infection with Leishmania parasites, which are transmitted by female phlebotomine sand flies. Although there are several types of leishmaniasis, the most common manifestation is CL.
CL causes skin sores with a variety of clinical presentations. They range from uncomplicated, self-healing skin lesions to debilitating, large, chronic recurring lesions. The lesions may be limited to the mouth or nose areas or may arise diffusely across the body. The sores typically progress from small bumps to open lesions with a raised border and central crater (ulcers).
Depending on the form and severity of the disease, CL can lead to severe social ostracization and, in some cases, physical disability, both of which may be detrimental to an affected individual reaching their true potential and result in financial hardship. Thus, although CL is not life-threatening, it can have devastating effects on local communities. The disfiguring skin lesions, which can leave life-long scars, lead to severe social stigma. This, in turn, can result in ostracism, disrupted education, and economic loss. These effects are especially severe since cutaneous leishmaniasis mostly affects people who already have only limited resources.1
Every year, there are approximately 600,000 to 1 million new cases of CL. The condition is endemic to Sri Lanka. 2.3 Unusually, in Sri Lanka, CL arises from infection with the Leishmania donovanizymodeme MON-37 parasite that is typically associated with visceral leishmaniasis. 4
Treatment of CL
Although there are treatments available for CL, their effectiveness can be as low as 50%. Furthermore, existing drugs have serious drawbacks in terms of safety, resistance, and availability. The drugs are not well tolerated, must be taken for a long time, and are difficult to administer. 5
The first-line drugs for CL are pentavalent antimonials, such as sodium stibogluconate (SSG). This has been the case for more than 70 years when pentavalent antimonial drugs were first introduced, and there has been little evidence of emerging novel effective treatments. 5
CL in Sri Lanka is particularly difficult to treat with current therapies, and even repeated intralesional or intramuscular administration of SSG can fail to achieve a response. 6 In successful cases, it can take months of daily or weekly treatment to achieve a cure, and patients commonly withdraw from treatment before this point.
There is thus an urgent need for a safe, topical or oral, well-tolerated, and affordable treatment for CL that can cure lesions and can be self-administered by the patients without the need for frequent visits to the clinic.
The predictive role of PD-L1 in leishmaniasis
A recent study investigated gene expression in samples from lesions and blood collected from patients in Sri Lanka with CL both at presentation and during SSG treatment 7 .
The lesion samples revealed that SSG treatment caused differential expression of immune-related genes, including immune checkpoint molecules. Spatial profiling and RNA fluorescence in situ hybridization (FISH) showed that the expression of PD-L1 and indoleamine 2,3-dioxygenase 1 (IDO1) proteins were reduced within the lesions during treatment. 7 Furthermore, these checkpoint molecules were expressed in higher quantities by parasite-infected immune cells than non-infected controls.
Researchers discovered that early reduction in PD-L1 (but not IDO1) expression was predictive of the rate of clinical cure (hazard ratio = 4.88) and paralleled the reduction in parasite load. It thus appears that the anti-leishmanial activity of antimonial drugs is achieved through the reduction in checkpoint inhibition on T cells. Since this new data indicate that PD-L1 expression is predictive of clinical response rate to SSG treatment in Sri Lankan patients with CL, it is possible that PD-L1 could represent a novel treatment approach for leishmaniasis.
StataQuest facilitates leishmaniasis research
TissueGnostics' StrataQuest™ is an advanced biomedical image processing and tissue cytometry solution for both brightfield and fluorescence images. 8 It can detect tissue structures, nuclei/cells, cellular compartments and can measure the proximities and spatial relationships on a digital slide. It integrates detected objects into detailed context-based quantitative analysis.
The StrataQuest contextual image analysis software was fundamental to the feasibility of this investigation. It enabled single-cell analysis, the analysis of co-expression of IDO1 and PDL1, and detection of the intracellular leishmaniasis parasite. 9
Quantification of IDO1, PD-L1, CD3 Amastin, and CD68 was performed using StrataQuest Analysis Software, which segmented nuclei based on the signal from the DAPI channel and then built and expanded a mask over staining of IDO-1/ PD-L1.
There is a great variety of streamlined analysis solutions StrataQuest Apps - available, which can be used for automated analysis. The vast potential of StrataQuest can be explored with the StrataQuest Apps . The IF Leishmaniasis APP detects intracellular Leishmania parasites based on DAPI staining and segments them in the detected host cells. 10 The number of parasites per cell is determined, and living and dead parasites can be distinguished (live/dead assays). The IF Dots APP enables the analysis of FISH-stained leishmaniasis parasites.
References and Further Reading
- Pires M, et al. The impact of leishmaniasis on mental health and psychosocial well-being: A systematic review. PLoS ONE 2019;14(10): e0223313. https://doi.org/10.1371/journal.pone.0223313
- Alvar J, et al. Leishmaniasis Worldwide and Global Estimates of Its Incidence. PLoS ONE 2012;7(5): e35671. https://doi.org/10.1371/journal.pone.0035671
- Athukorale DN, et al. Locally acquired cutaneous leishmaniasis in Sri Lanka. J Trop Med Hyg. 1992;95(6):432–433.
- Ranasinghe S, et al. Leishmania donovani zymodeme MON-37 isolated from an autochthonous visceral leishmaniasis patient in Sri Lanka, Pathogens and Global Health2012;106:7, 421-424. https://www.tandfonline.com/doi/full/10.1179/2047773212Y.0000000054
- Drugs for Neglected Diseases Initiative. Cutaneous leishmaniasis. https://dndi.org/diseases/cutaneous leishmaniasis.
- Refai FW, et al. Nonresponsiveness to standard treatment in cutaneous leishmaniasis: A case series from Sri Lanka. Trop Parasitol 2016;6:155-8.
- Nidhi S, et al. Early reduction in PD-L1 expression predicts faster treatment response in human cutaneous leishmaniasis. J Clin Invest. 2021;131(22):e142765. https://doi.org/10.1172/JCI142765
- https://tissuegnostics.com/products/contextual-image-analysis/strataquest
- Nidhi S, et al. Supplementary data. https://www.jci.org/articles/view/142765/sd/1
- Schmid M et al, An Emerging Approach for Parallel Quantification of Intracellular Protozoan Parasites and Host Cell Characterization Using TissueFAXS Cytometry. PLOSone. 2015, 10 (10);